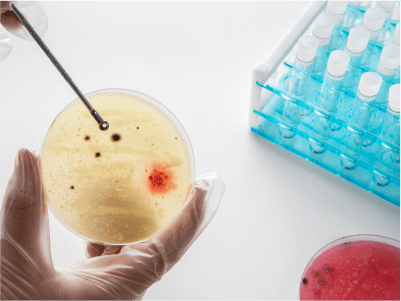
Pruebas Microbiológicas con Filtración por Membrana: Precisión, Rapidez y Fiabilidad para el Control de Calidad

Guía de seguridad: Cómo calentar material de vidrio en el laboratorio sin correr riesgos
En el día a día del laboratorio, el uso de material de vidrio es tan común que a menudo olvidamos los riesgos asociados a su manipulación térmica. Incluso cuando utilizamos recipientes diseñados específicamente para soportar altas temperaturas, un error mínimo en el procedimiento puede terminar en cristales rotos, pérdida de muestras costosas o, peor aún, accidentes del personal.
No toda la cristalería de laboratorio reacciona igual ante el fuego o las placas de calor. La resistencia depende directamente de los materiales de fabricación y de los estándares de calidad del fabricante. Por ejemplo, el vidrio de borosilicato cuenta con un coeficiente de dilatación térmica muy inferior al del vidrio de sílice-soda (vidrio común), lo que lo hace mucho más apto para el choque térmico. Sin embargo, marcas de alta gama como DURAN®, WHEATON®, PYREX® y KIMBLE® ofrecen garantías superiores debido a la uniformidad en el grosor de sus paredes, un factor crítico para evitar tensiones internas.
Independientemente de la marca que utilices, la seguridad depende de la técnica. A continuación, te compartimos 5 consejos esenciales para calentar material de vidrio de forma segura en tu sitio de trabajo.
- Controla la expansión y contracción térmica a altas temperaturas
Aunque el vidrio de borosilicato posee un coeficiente de expansión térmica sumamente, esto no lo hace indestructible.
Cuando trabajes con temperaturas que superen los 150 °C, el proceso de calentamiento y el posterior enfriamiento deben realizarse con extrema lentitud. Programa tus equipos para que los aumentos y descensos de temperatura sean graduales. El tiempo y la paciencia son tus mejores aliados para evitar que la estructura molecular del vidrio sufra fatiga.
- Despídete del choque térmico
El choque térmico ocurre cuando un material experimenta un cambio drástico de temperatura en pocos segundos. Una transición brusca puede agrietar el recipiente de inmediato.
- La regla de oro: Calienta el vidrio de manera suave desde el primer momento.
- Al terminar: Nunca coloques un matraz hirviendo sobre una superficie fría o expuesto a corrientes de aire directas. Deja que se enfríe poco a poco en una zona templada y protegida.
- Distribuye el calor uniformemente y evita los «puntos calientes»
La concentración de calor directo en una sola zona del vaso o matraz genera tensiones diferenciales extremas en el material, debilitándolo hasta romperlo. Para mitigar este riesgo, adapta tu método según el equipo que uses:
- Mechero Bunsen: No apliques la llama directamente sobre el cristal. Utiliza siempre una rejilla metálica con centro cerámico para difundir el fuego de manera homogénea.
- Parrilla de calefamiento: Asegúrate de que la superficie de la placa sea más grande que la base del recipiente que vas a calentar. Esto garantiza que la base reciba calor uniforme. Además, recuerda introducir el recipiente siempre a temperatura ambiente; colocar un frasco frío sobre una placa ya caliente es una receta directa para el choque térmico.
- Precauciones estrictas al usar el microondas
El microondas es una herramienta rápida, pero sumamente selectiva. El vidrio sódico-cálcico tradicional está prohibido en este equipo debido a su incapacidad para absorber cambios térmicos súbitos.
Si utilizas vidrio de borosilicato (que sí es apto), asegúrate siempre de que el recipiente contenga una sustancia capaz de absorber las microondas. Asimismo, revisa minuciosamente los accesorios acoplados: los tapones, juntas o conectores de plástico deben estar fabricados obligatoriamente de materiales resistentes como el polipropileno o el PTFE.
- Esterilización en autoclave: Protege el vidrio para sus usos futuros
El proceso de esterilización en autoclave puede debilitar silenciosamente el material si no se realiza correctamente, comprometiendo su resistencia para los siguientes calentamientos en el laboratorio. Sigue estas pautas:
- Afloja las tapas de rosca: Jamás introduzcas un recipiente herméticamente cerrado. La diferencia de presión interna y externa puede deformar o fracturar el vidrio. Si necesitas mantener la esterilidad del gas durante el intercambio, utiliza tapas especializadas con membranas de ventilación estériles.
- No satures el equipo: Evita sobrecargar la cámara del autoclave. Mantener un espacio prudente entre cada objeto garantiza una circulación óptima del vapor a alta presión y previene impactos físicos indeseados entre las piezas de cristal.
Conclusión
La prevención en el laboratorio comienza con el conocimiento de las herramientas. Al combinar materiales de alta calidad con procedimientos térmicos graduales y controlados, no solo prolongarás la vida útil de tus instrumentos de medición y contención, sino que garantizarás un entorno de trabajo significativamente más seguro para todo tu equipo.
GVAZQUEZ EQUIP&LAB ofrece una gama completa de accesorios y equipo de calentamiento para laboratorios de las industrias, ciencias de la vida, investigación, docencia, privados, etc. Solicite más información sobre este material.

Comparte
GVAZQUEZ, siempre presente

Guía técnica: Filtración por membrana
Guía técnica: Filtración por membrana